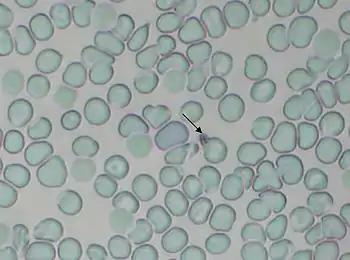

Микроядро (цитология)
Микроядро — в цитологии фрагмент ядра в эукариотической клетке, не содержащий полного генома, необходимого для её выживания. Является патологической структурой и может наблюдаться в клетках любых тканей. Обычно микроядра образуются в результате неправильного хода клеточного деления или фрагментации ядра в процессе апоптоза.

Другое значение — ядро в составе клетки простейших, принадлежащих к типу инфузории. Данные простейшие отличаются ядерным дуализмом: наличием крупного вегетативного ядра — макронуклеуса (макроядро), и генеративного ядра — микронуклеуса (микроядро).
Причины возникновения


Микроядра образуются в процессе клеточных делений из: отстающих ацентрических фрагментов, возникших при разрыве хромосом (так называемый кластогенный эффект); отстающих хромосом (так называемый анеугенный эффект). В основном выделяют три типа нарушения нормального процесса формирования ядра:
- Микроядра «стандартного» типа, небольшого размера, хорошо оформлены и находятся близко от основного ядра или на некотором удалении от него, иногда даже на периферии клетки.
- Микроядра «основного» типа, не отличающиеся по размеру от основного ядра, зачастую в непосредственной близости друг к другу.
- В редких случаях — неоформленный хромосомный материал, который представляет собой расположение хромосом в метафазе митоза.
На данный момент конкретные факторы формирования микроядер из неоформленного хромосомного материала досконально не известны. Сами же причины, определяющие нарушения в процессе деления, приводящие к образованию микроядер, можно связать с факторами, обладающими статокинетичекским действием (задерживающими и вызывающими нарушения в фазах митоза, связанных с формированием веретена деления и расхождением хромосом). В различных исследованиях Ильинских и других авторов показано, что такие нарушания могут быть связаны с широким спектром факторов, начиная от воздействия тяжёлых металлов, действия ионизирующего излучения и заканчивая вирусными инфекциями.
Механизмы формирования
Микроядра возникают из фрагментов хромосом, которые лишены центромер и поэтому исключаются из клеточных ядер в момент деления клеток. Иными словами, они являются ацентрическими фрагментами, возникшими в результате структурных нарушений хромосом и не попавшими во вновь формирующееся ядро при делении клеток. Кроме того, они могут образовываться из хромосом, оставшихся в анафазе.
Использование в биоиндикации и биотестировании
Микроядерный тест (МЯ тест)

Разработку микроядерного теста обычно связывают с именем Шмидта, который был предложен им в 1970 году, хотя этот тест был предложен одновременно в 1970—1973 гг. несколькими группами исследователей. Было показано, что микроядерный тест (МЯ тест) по чувствительности не уступает тесту по изучению хромосомных аберраций в клетках костного мозга животных, являясь одновременно гораздо менее трудоемким.
Микроядерный тест является относительно новым, но уже общепринятым цитогенетическим методом оценки мутагенного действия агентов различной природы. С помощью этого метода проведено тестирование на мутагенную активность большого числа химических, физических и биологических агентов, тест применяется уже на первом этапе проверки потенциальных мутагенов и канцерогенов.
К преимуществам микроядерного теста следует отнести быстроту, независимо от исследования кариотипа вида, нередко содержащего большое число мелких плохо различимых хромосом, надежность, а также то, что тестирование можно проводить в тканях с низкой митотической активностью. Микроядерный анализ проводят в безъядерных эритроцитах, в клетках эмбрионов, в сперматидах, оотидах, что особенно важно при прогнозе возможных последствий для наследственности потомства. В экологической генетике данный тест используется для оценки мутагенного эффекта факторов среды при различных техногенных авариях, экологических катастрофах, связанных с мощными выбросами загрязняющих веществ в окружающую среду, а также при обследовании рабочих, связанных с вредными производствами.
В частности, примером могут служить многолетние исследования последствий радиационного воздействия испытаний на Семипалатинском полигоне, Томского радиоактивного следа, аварии на Чернобыльской АЭС. Проведенные исследования демонстрируют повышенную частоту МЯ в клетках периферической крови и слизистой оболочки рта (букальный эпителий) у лиц, подвергшихся действию радиации. Использование микроядерного теста в экспериментах на животных, в частности, на бурых лягушках в условиях хронического радиационного воздействия в окрестностях ЧАЭС позволяет рассматривать данный критерий как один из показателей экологических условий среды обитания организмов. Это подтверждают и данные по повышенному уровню цитогенетических повреждений, на основании МЯ теста, в незрелых эритроцитах костного мозга европейской рыжей полевки, природные популяции которой в течение более 20-ти поколений, после Чернобыльской аварии, обитают на радиационно загрязненных территориях. Помимо оценки мутагенного действия ионизирующей радиации МЯ, тест является чувствительным к генотоксическому эффекту ряда химических соединений, которые часто выступают компонентами загрязнения окружающей среды. Так, было показано, что у людей, работающих на производстве хлорфеноксигербицидов, достоверно повышена частота микроядер в клетках эпителиальных и слизистых тканей. Также исследованию МЯ тестом могут подвергаться лекарственные препараты.
Литература
- Войтович А. М., Елисеева К. Г. Микроядра в периферической крови бурых лягушек как тест на хронические мутагенные воздействия. // Объем и методы генотоксической оценки и побочных эффектов биологически активных веществ: тез. докл. Всесоюз. симп. — Л., 1989.
- Жулева Л. Ю. «Повреждение хромосомного аппарата соматических клеток человека при воздействии диоксина» Автореферат дисс. канд. биол. наук. М. 2000 г. 21 с.
- Ильинских Н. Н., Ильинских И. Н., Новицкий В. В., Ванчугова Н. Н. «Микроядерный анализ и цитогенетическая нестабильность» Томск, Изд. Томского ун-та 1992 г. 272 с.
- Свирновский А. И., Шаманская Т. В., Бакун А. В. и др. О гематологических и цитогенетических показателях у лиц, пострадавших в результате аварии на Чернобыльской АЭС. // 2-я Междунар. конф.: Отдаленные медицинские последствия Чернобыльской катастрофы, Киев, Украина, 1-6 июня, 1998 г. Киев. 1998. С.360.
- Чемикосова Т. С., Камалова О. А., Ибрагимова З. Н. Состояние слизистой оболочки рта у лиц, профессионально контактирующих с хлорфеноксигербицидами. // Стоматология 1999. 25-28.
- Adler I. D., Klish U., van Humelen P., Kirsh-Volders M. «Mice micronucleus test with known suspect spindle position: results from two laboratories»// Mutagenesis, 1991, Vol. 6, p. 47-53.
- Auletta A. E., Dearfield K. L., Cimino M. C. «Mutagenicity test schemes and guidelines: US EPA Office of Polution Prevention and Toxics and Office of Pesticide Programs»// Environm. Mol. Mutagen, 1993, Vl. 21, p. 38-45.
- Boller K. Schmid W. Chemishe Mutagenese beim Sauger. Das Knochermark des Chineschen Hamsters als in vivo-Test system. Haematologische Befunde nach Behandlung mit Trenimonю // Humangenetik 11: 1970. 35-54
- Heddle J.A. A rapid in vivo test for chromosomal damage // Mut. Res. 18: 1973. 187—190